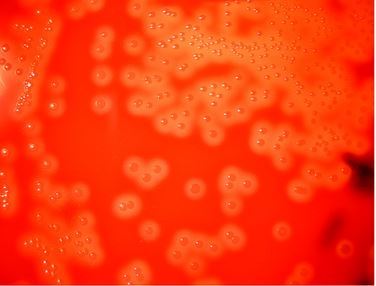
- Beta Hemolysis in Sheep Blood Agar.

Streptococci are Gram-positive cocci either diplococci (lanceolate shaped; S. pneumoniae) or in chains. They are catalase-negative (an important test to differentiate streptococci from Staphylococci). These fastidious gram-positive coccimay give either alpha or beta or gamma hemolysis when cultured on blood agar.
β-hemolytic streptococci produce hemolysins that lyse the sheep RBCs (poorly lyse human RBCs too), resulting in a clearing of the Blood Agar plate surrounding the colonies. More intense β-hemolysis is noted in areas where the medium has been “stabbed,” pushing some of the bacteria under the surface of the medium. The β-hemolysis in these areas is due to the combined action of both hemolysins of Streptococci (Streptolysin O and Streptolysin S. The surface β-hemolysis is largely due to streptolysinS(oxygenstable hemolysin), as Streptolysin O which is oxygen-labile does not show maximal activity on the surface of the agar.
Serologic grouping of cell wall carbohydrates of Streptococci was classically been used to identify species of beta-hemolytic Streptococci, this grouping is known as  Lancefield grouping. Beta hemolytic streptococci are arranged into twenty (20) groups A-U without I and J (i.e. A through H and K through V). Rebecca Lancefield, a prominent American microbiologist, introduced Lancefield grouping.

The basis of Lancefield grouping is the antigenic differences in C carbohydrates, a group-specific antigen. Â C carbohydrate is located in the cell wall of streptococci
(Note:viridansstreptococci and Streptococcus pneumoniae have no group-specific antigen).
The original Lancefield precipitin test is now rarely performed in clinical laboratories. Now, it has been replaced by either latex agglutinationor coagglutination.
Group A Streptococci (GAS)
Streptococcus pyogenes, is one of the most important human pathogens which causes Streptococcal sore throat, skin infections, and post-streptococcal sequelae such as rheumatic fever and post-streptococcal glomerulonephritis (PSGN). S. pyogenes isinhibited by the antibiotic bacitracin, an important diagnostic criterion.
Group B Streptococci
Streptococcus agalactiaecolonizes the genital tract of some women and can cause neonatal meningitis and sepsis. It can cause septic abortion and puerperal or gynecological sepsis and occasionally urinary tract infections. S. agalactiae gives CAMP test positive and canhydrolyze the hippurate.
Group C Streptococci
 Group C beta-hemolytic streptococci currently include S. dysgalactiae subsp. equisimilis and other related strains under the same species or S. equisubspecies. S. dysgalactiae subsp. equisimilishas been recovered from pharyngitis and tonsillitis from patients with underlying diseases such as cardiopulmonary disease, diabetes, immunosuppression, HIV, etc.
Group D Streptococci
It include enterococci (e.g., Enterococcus faecalis and Enterococcus faecium) and nonenterococci (S. bovis). Enterococci are members of the normal flora of the colon. They can cause urinary, biliary, and cardiovascular infections.
Note: By the mid-1980s, the enterococcal streptococci (Lancefield group D) had taken up residence in their own newly created Enterococcus genus and the “dairy” or “lactic” streptococci (Lancefield group N) were moved to new Lactococcus genus.
Group F Beta Hemolytic streptococci
Organisms of this group have been called S. milleri in the British taxonomic scheme and anginosus (S. anginosus) group in the American taxonomic group. Â Group F Beta-hemolytic streptococci are recognized as a cause of severe suppurative infections including cellulitis, deep-tissue abscesses, bacteremia, osteomyelitis, and endocarditis.
Group K-U contains streptococcal species of limited virulence which can cause infections in immunocompromised individuals.
Summary of Medically Important Streptococci
References
| Species | Lancefield Group | Typical Hemolysis | Important Lab Characteristics |
|---|---|---|---|
| Streptococcus pyogenes | A | Beta | Bacitracin sensitive PYR Test positive |
| S. agalactiae | B | Beta | Bacitracin resistant Hippurate utilized CAMP test positive |
| Enterococcus faecalis | D | Alpha, Beta or None | Growth in 6.5% NaCl PYR Test positive |
| S. bovis | D | Alpha or none | No growth in 6.5% NaCl |
| S. pneumoniae | Not groupable | Alpha | Bile soluble Inhibited by optochin |
| Viridans group | Not groupable | Alpha | Not bile soluble Not inhibited by optochin |
- Winn, W. C., & Koneman, E. W. (2006). Koneman’s Color Atlas and Textbook of Diagnostic Microbiology (Color Atlas & Textbook of Diagnostic Microbiology). Lippincott Williams & Wilkins
- Bailey & Scott’s Diagnostic Microbiology, Forbes, 11th edition
- Şahan Yapicier, Ö., Sababoglu, E., Ozturk, D., Turutoglu, H., Pehlivanoglu, F., & Kaya, M. (2021). Lancefield classification and antimicrobial resistance of hemolytic streptococci isolated from bovine mastitis. Veterinaria italiana, 57(1), 41–47. https://doi.org/10.12834/VetIt.1855.9879.3 Facklam, R. F., Martin, D. R., Lovgren, M., Johnson, D. R., Efstratiou, A., Thompson, T. A., Gowan, S., Kriz, P., Tyrrell, G. J., Kaplan, E., & Beall, B. (2002). Extension of the Lancefield classification for group A streptococci by addition of 22 new M protein gene sequence types from clinical isolates: emm103 to emm124. Clinical infectious diseases : an official publication of the Infectious Diseases Society of America, 34(1), 28–38. https://doi.org/10.1086/324621